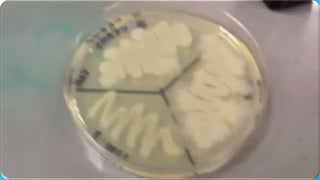

This document discusses the biodegradation of starch by microorganisms. It begins by defining biodegradation and starch. Starch is made of amylose and amylopectin and can be degraded aerobically or anaerobically. Many bacteria and fungi produce amylase enzymes that break down starch into simpler sugars like maltose and glucose. The document then covers the industrial applications of starch degradation in food processing, brewing, textiles, fuel production, detergents, and more. Key microbes used include Bacillus species, Aspergillus, and Saccharomyces.